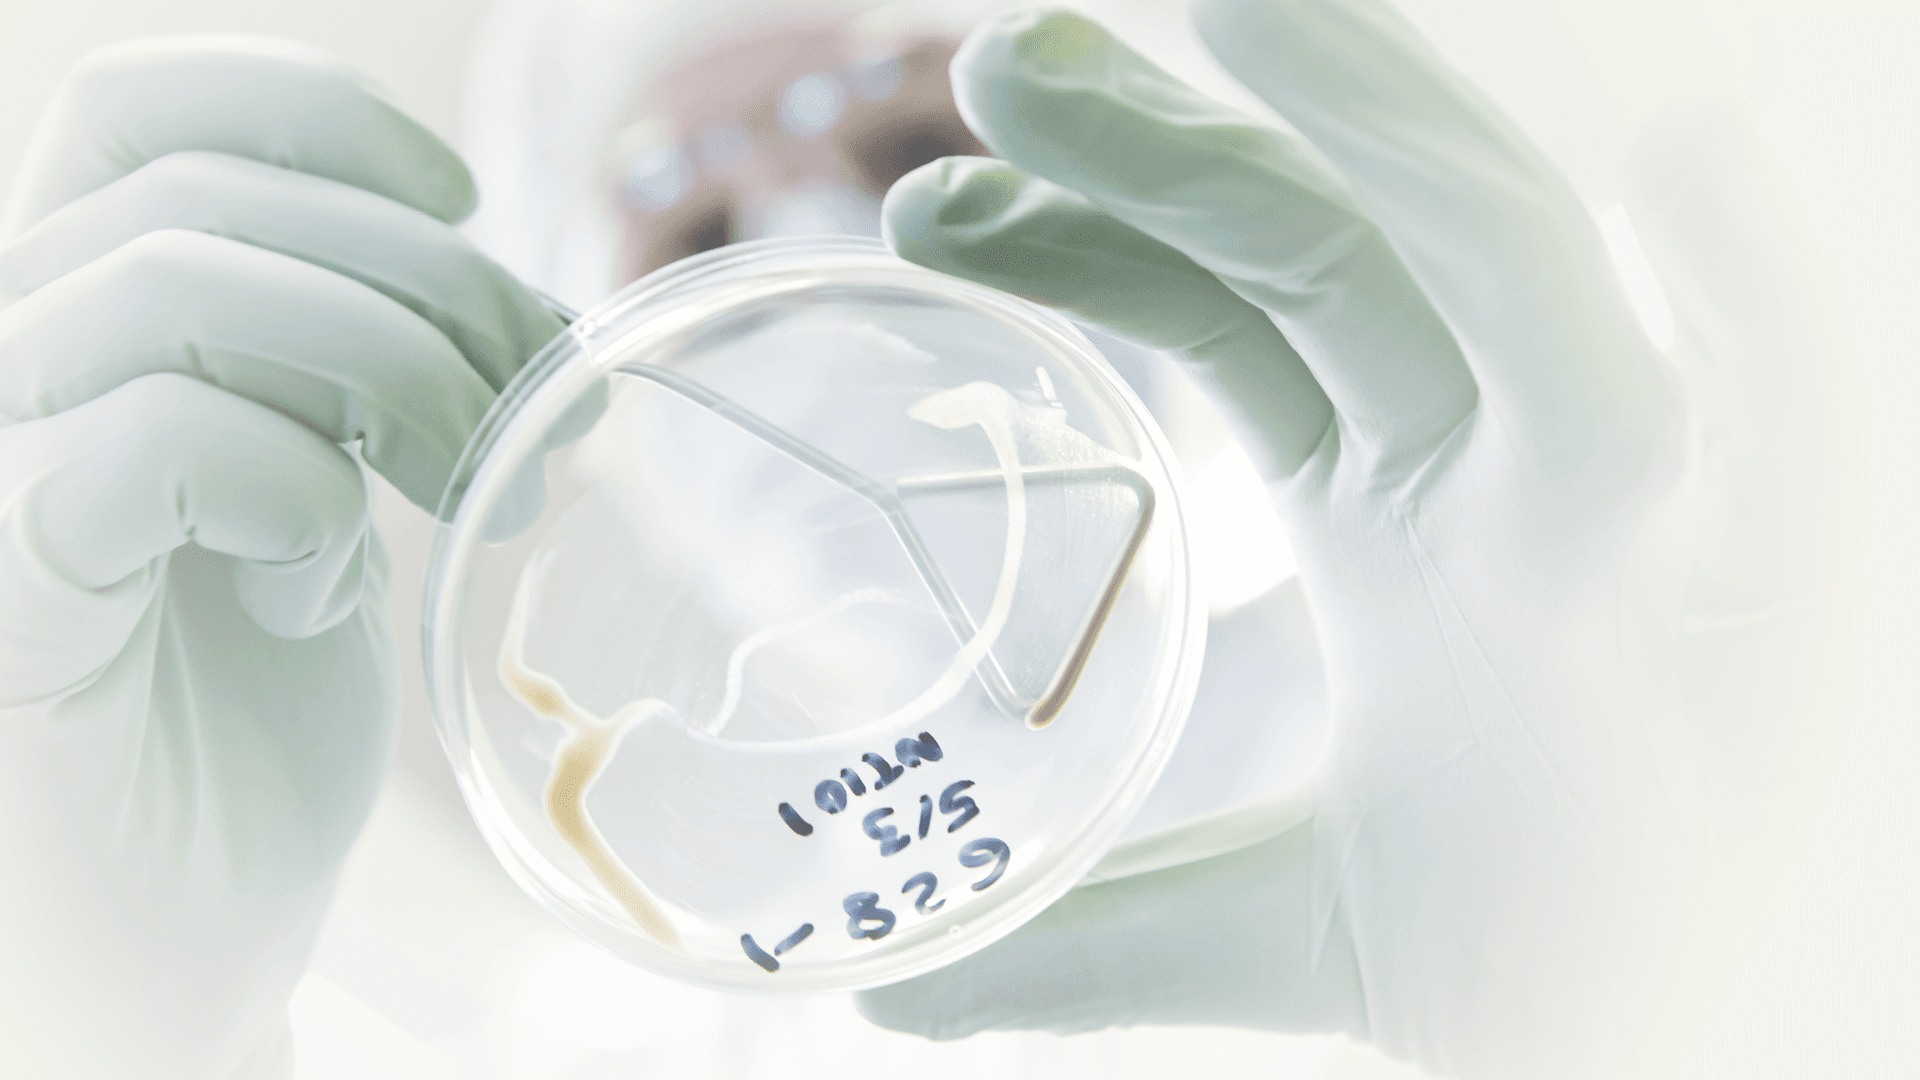
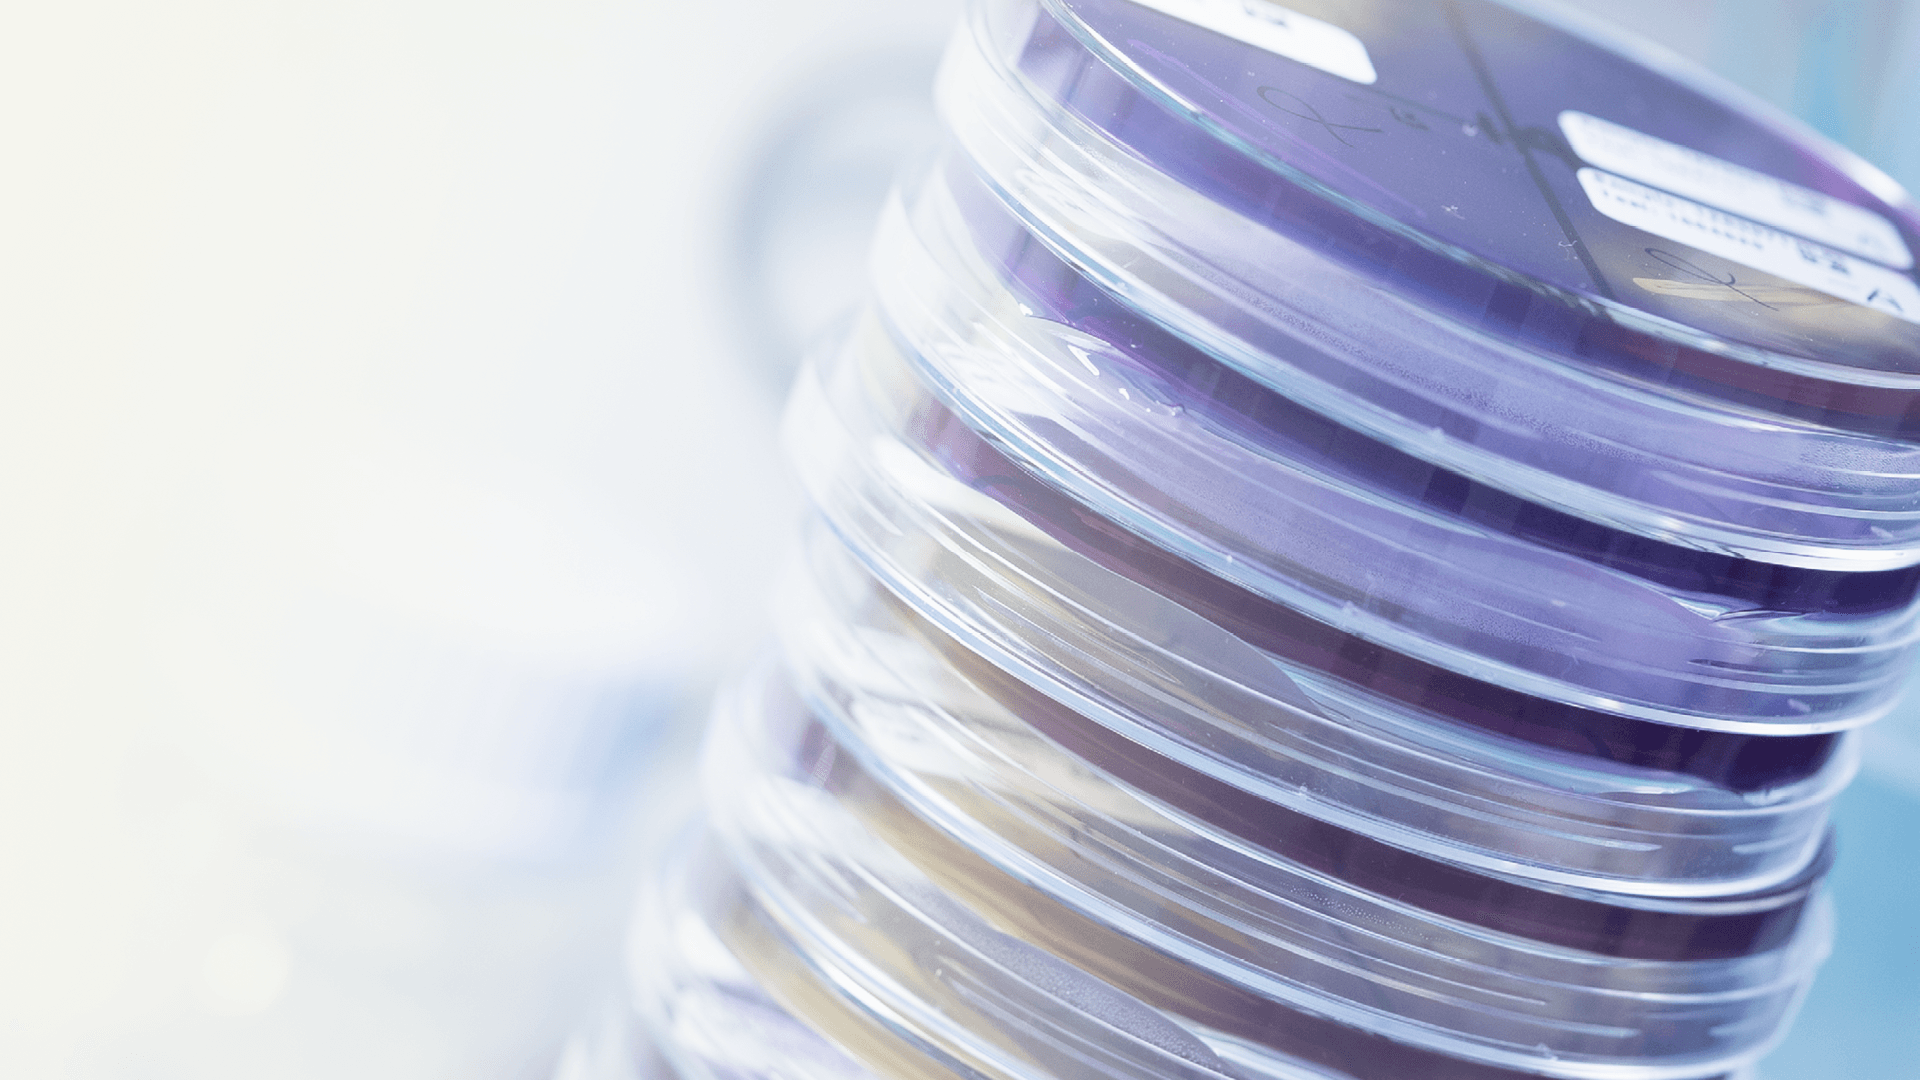

About us
Our purpose is to save lives by supplying critical anti-infectives to the world.
Our goal is to be world leaders in lifecycle management of fermentation-based, non-beta-lactam anti-infectives to sustainably provide these treatments to patients around the world.
Meet the Xellia Executive Committee and our Board of Directors
Leadership teams
Xellia Pharmaceuticals is wholly owned by Novo Holdings A/S since 2013.

More than 120 years of experience in the pharmaceutical industry
Our heritage
Xellia is a world leader in delivering critical care therapies and anti-infective solutions for severe and often life-threatening infections, encompassing Active Pharmaceutical Ingredients (APIs) and Finished Dosage Forms (FDFs).

Join our team
The “all hands on deck” workplace.
At Xellia, you get a rare opportunity. The chance to shape yourself, our company and society.